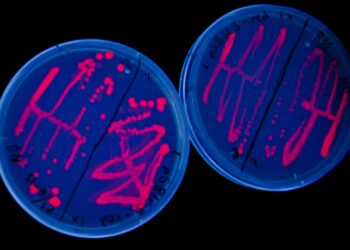

Le statut moral des «êtres fabriqués» débattu
La biologie synthétique veut créer «de novo» ou «reprogrammer» des organismes dans un but précis. Mais comment l’homme doit-il considérer moralement ces êtres «créés»? La Commission fédérale d’éthique donne son ...